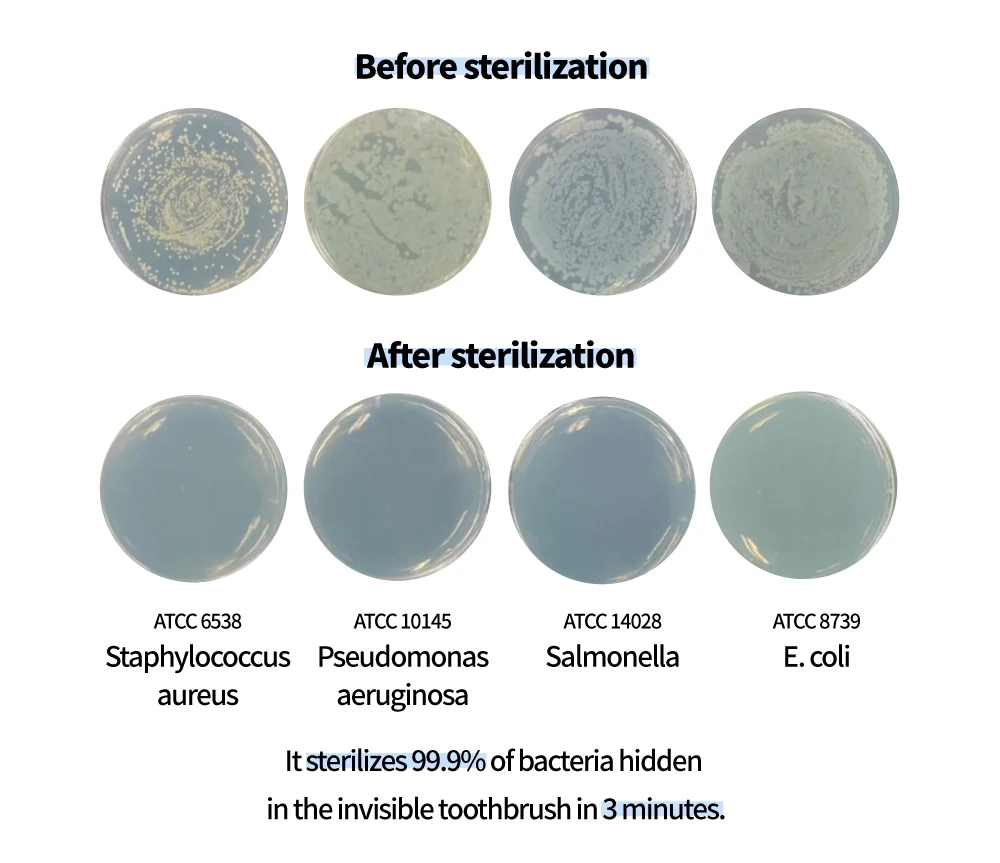

Share on:
Product name | wall mounted uv toothbrush sanitizer |
Function | toothbrush holder,uvc sterilization,brushing teeth timer,digital clock |
Sterilizing Method | UV-C Light |
Product size | 57.6*160.6*38.5mm |
Charging type | Micro USB 5pin |
Battery | 1500mA LI-polymer Battery |
Support Power | 5V 1A USB adapter support up to 5V 2A |